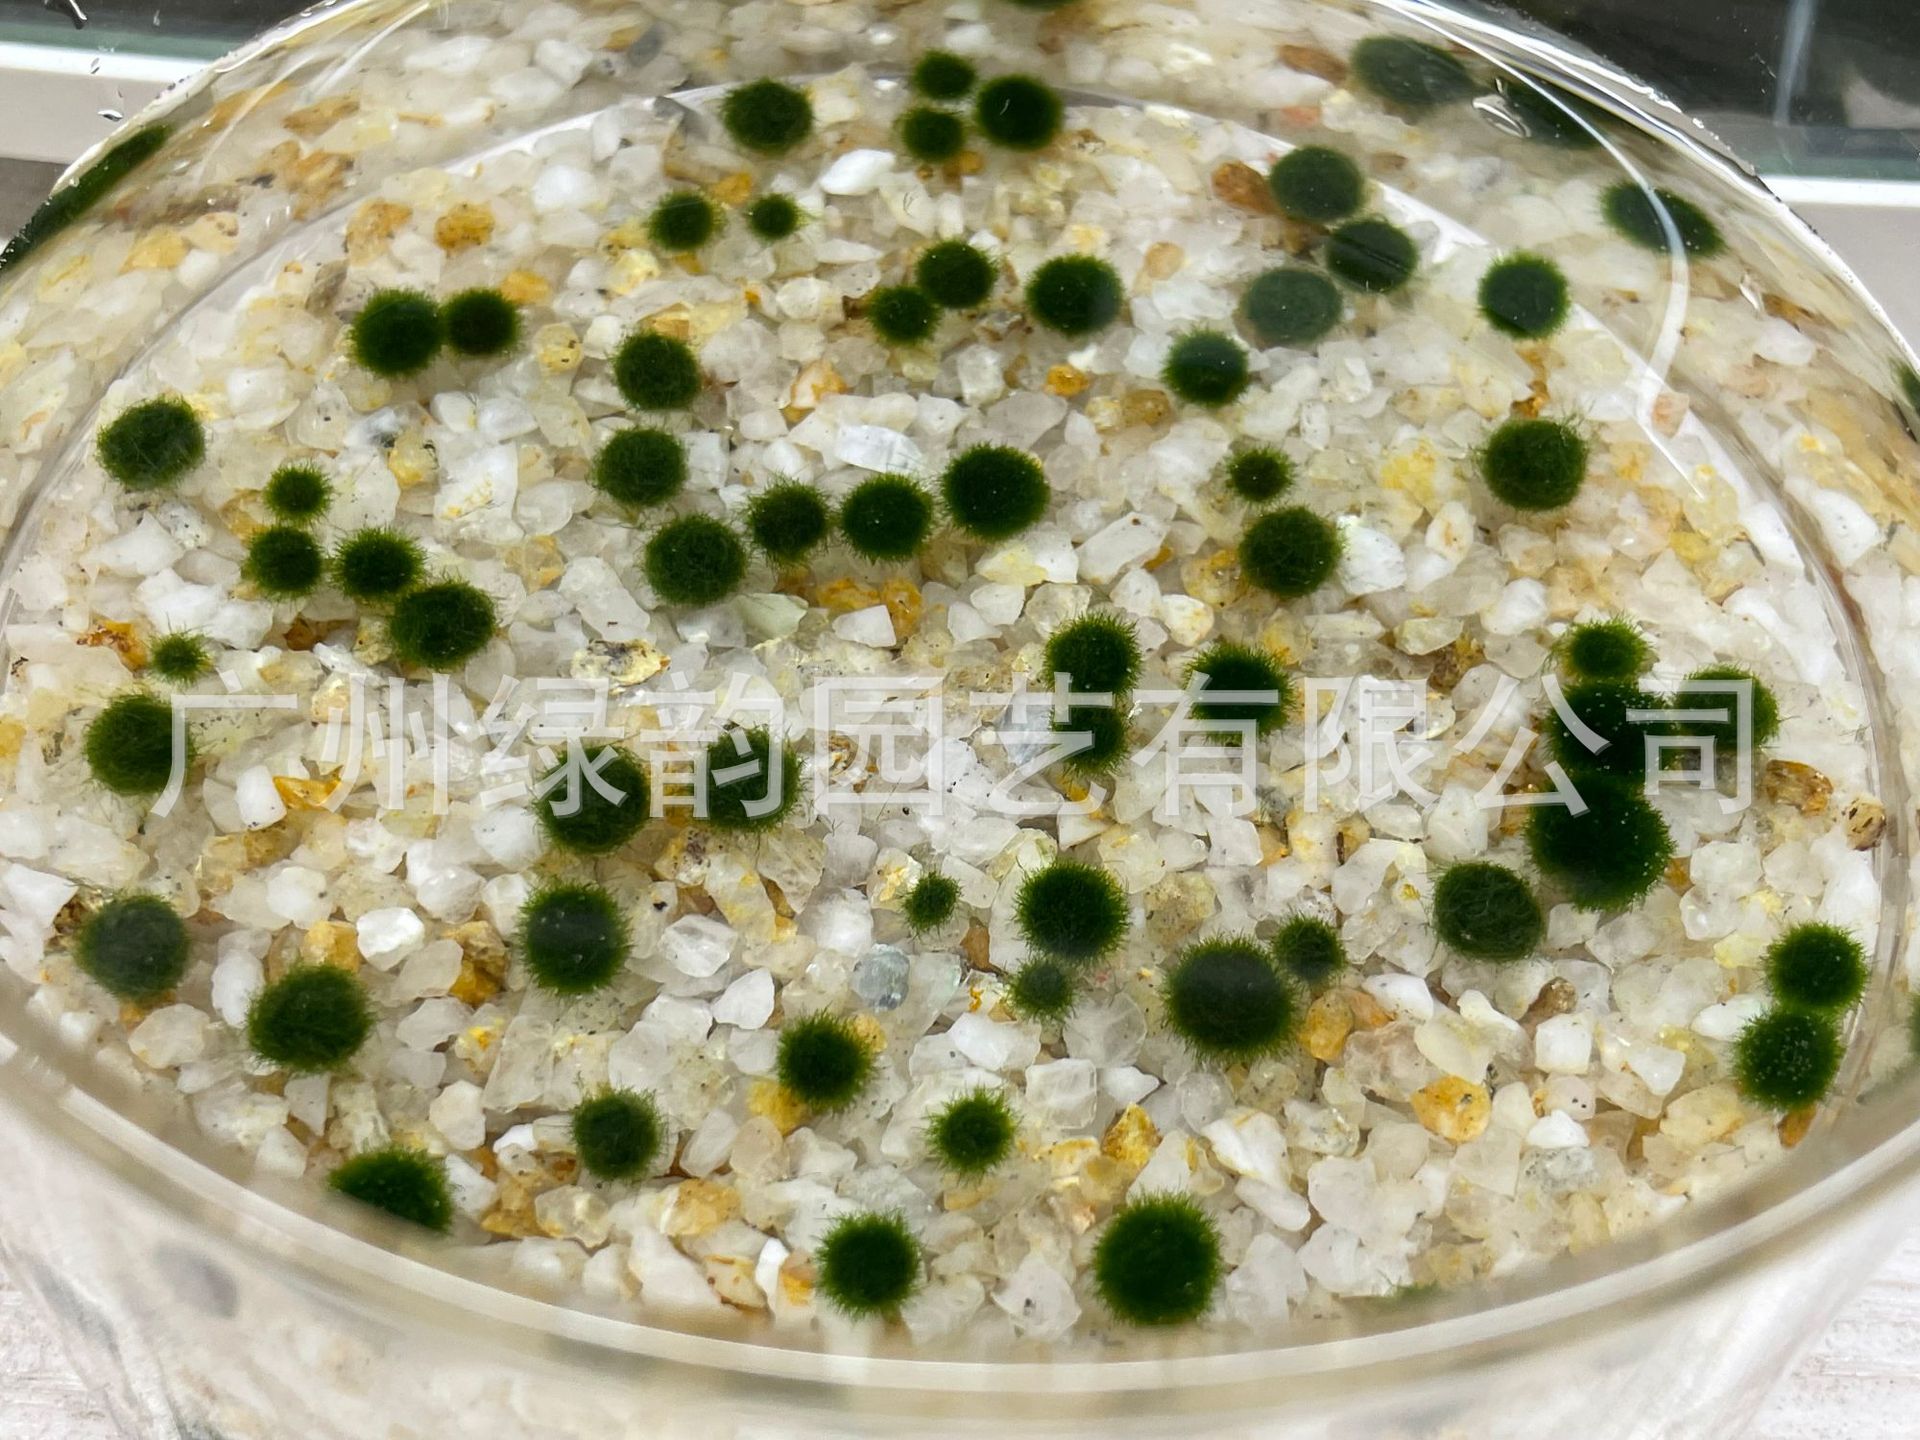
9898c97d7a24a85a5cfd019933d891

Шар морских водорослей маримо, живые декоративные водные растения, оптовая продажа микроландшафта для аквариума
Цена
¥0.59 / ≈ 7 ₽
MOQ: 1 pcs
1шт - ¥0.59
Продавец
广州绿韵园艺有限公司
Рейтинг
4.9
Продано
1
Всего
В наличии
1944052
SKU суммарно
Offer ID: 670427708340
Оформить заказ
Цвет:
| Изображение | Цвет | Цена (CNY / RUB) | В наличии | SKU ID | Кол-во / Корзина |
|---|---|---|---|---|---|
📦 | 0.1 years old 1 (0.3~0.5cm) | ¥0.59 / ≈ 7 ₽ | 81888 | 4859398024265 | |
📦 | Half year old (0.9~1cm) | ¥1.35 / ≈ 16 ₽ | 73843 | 4906694808560 | |
📦 | 1 year old (1.1~1.2cm) | ¥1.59 / ≈ 19 ₽ | 93543 | 4906694808559 | |
📦 | 2 years old (1.2~1.4cm) | ¥2.28 / ≈ 28 ₽ | 97451 | 5296995340017 | |
📦 | 4 years old (1.5-1.7cm) | ¥7.98 / ≈ 96 ₽ | 99490 | 5296995340016 | |
📦 | 6 years old (2cm) | ¥46.0 / ≈ 556 ₽ | 99992 | 4906694808553 | |
📦 | 8 years old (2.2cm) | ¥85.0 / ≈ 1 027 ₽ | 100000 | 4906694808554 | |
📦 | 0.3 years old (0.6-0.8cm) | ¥0.98 / ≈ 12 ₽ | 98686 | 4906694808551 | |
📦 | 3 years old (1.4~1.5cm) | ¥6.48 / ≈ 78 ₽ | 99976 | 4906694808556 | |
📦 | 6 in March (0.6~0.8cm) | ¥8.38 / ≈ 101 ₽ | 99941 | 4906694808552 | |
📦 | Half-year-old 4 (0.9~1cm) | ¥5.7 / ≈ 69 ₽ | 99902 | 4906694808550 | |
📦 | 1 year old 3 (1.1~1.2cm) | ¥5.12 / ≈ 62 ₽ | 99871 | 4906694808547 | |
📦 | 2 (1.3~1.4cm) | ¥4.55 / ≈ 55 ₽ | 99867 | 4906694808549 | |
📦 | 2 4 years old (1.6-1.8cm) | ¥25.0 / ≈ 302 ₽ | 99992 | 4906694808548 | |
📦 | Half +1+2 years old | ¥5.88 / ≈ 71 ₽ | 99985 | 4825377148350 | |
📦 | Half +1+2+4 years old | ¥18.52 / ≈ 224 ₽ | 99990 | 4825377148351 | |
📦 | 1+2+3 years | ¥11.65 / ≈ 141 ₽ | 99990 | 4825377148352 | |
📦 | Limit: 2 (0.6~0.8cm) for 0.3 years old | ¥2.65 / ≈ 32 ₽ | 99809 | 4906694808555 | |
📦 | 0.1 years old 3 | ¥3.15 / ≈ 38 ₽ | 99885 | 5043331066901 | |
📦 | 0.3 years old 3 | ¥4.18 / ≈ 51 ₽ | 99951 | 4933704769233 |
Статистика продавца
3.5
Сервис
Источник: API 1688
1.5
Логистика
Источник: API 1688
5.0
Споры
Источник: API 1688
5.0
Оформление
Источник: API 1688
4.0
Консультация
Источник: API 1688
59%
Повторные покупки
Источник: API 1688
3.0
Постпродажное
Источник: API 1688
76%
Ответ ≤48ч (30д)
Источник: API 1688
0%
Возврат по качеству (30д)
Источник: API 1688
Свойства товара
Происхождение Guangzhou
Номер товара Seaweed Ball
Нужно ли импортировать No
Типы водных растений и удобрений Seaweed Ball
Функция Beautiful
Бренд Green Rhyme Gardening
Является ли источник трансграничного экспорта эксклюзивным No
Стиль Japanese Marimo
Стилизация Round (unfried)
Упаковка several grain bag
Категория продукта water grass
Описание товара